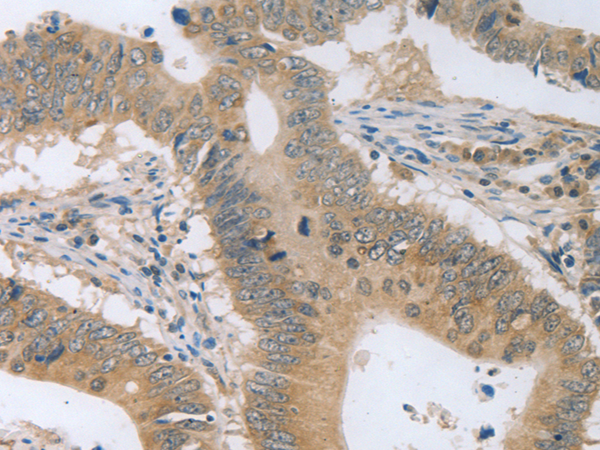

中文名稱: 兔抗P2RY11多克隆抗體
英文名稱: Anti-P2RY11 rabbit polyclonal antibody
別 名: P2Y11
相關(guān)類別: 一抗
儲(chǔ) 存: 冷凍(-20℃)
宿 主: Rabbit
抗 原: P2RY11
反應(yīng)種屬: Human
標(biāo) 記 物: Unconjugate
克隆類型: rabbit polyclonal
技術(shù)規(guī)格
|
Background: |
The product of this gene belongs to the family of G-protein coupled receptors. This family has several receptor subtypes with different pharmacological selectivity, which overlaps in some cases, for various adenosine and uridine nucleotides. This receptor is coupled to the stimulation of the phosphoinositide and adenylyl cyclase pathways and behaves as a selective purinoceptor. Naturally occuring read-through transcripts, resulting from intergenic splicing between this gene and an immediately upstream gene (PPAN, encoding peter pan homolog), have been found. The PPAN-P2RY11 read-through mRNA is ubiquitously expressed and encodes a fusion protein that shares identity with each individual gene product. |
|
Applications: |
ELISA, WB, IHC |
|
Name of antibody: |
P2RY11 |
|
Immunogen: |
Synthetic peptide of human P2RY11 |
|
Full name: |
purinergic receptor P2Y, G-protein coupled, 11 |
|
Synonyms: |
P2Y11 |
|
SwissProt: |
Q96G91 |
|
ELISA Recommended dilution: |
500-1000 |
|
IHC positive control: |
Human colon cancer and human brain |
|
IHC Recommend dilution: |
25-100 |
|
WB Predicted band size: |
40 kDa |
|
WB Positive control: |
Human fetal brain tissue,293T and Hela cell lysates |
|
WB Recommended dilution: |
500-2000 |

購(gòu)物車
購(gòu)物車 幫助
幫助
 021-54845833/15800441009
021-54845833/15800441009
